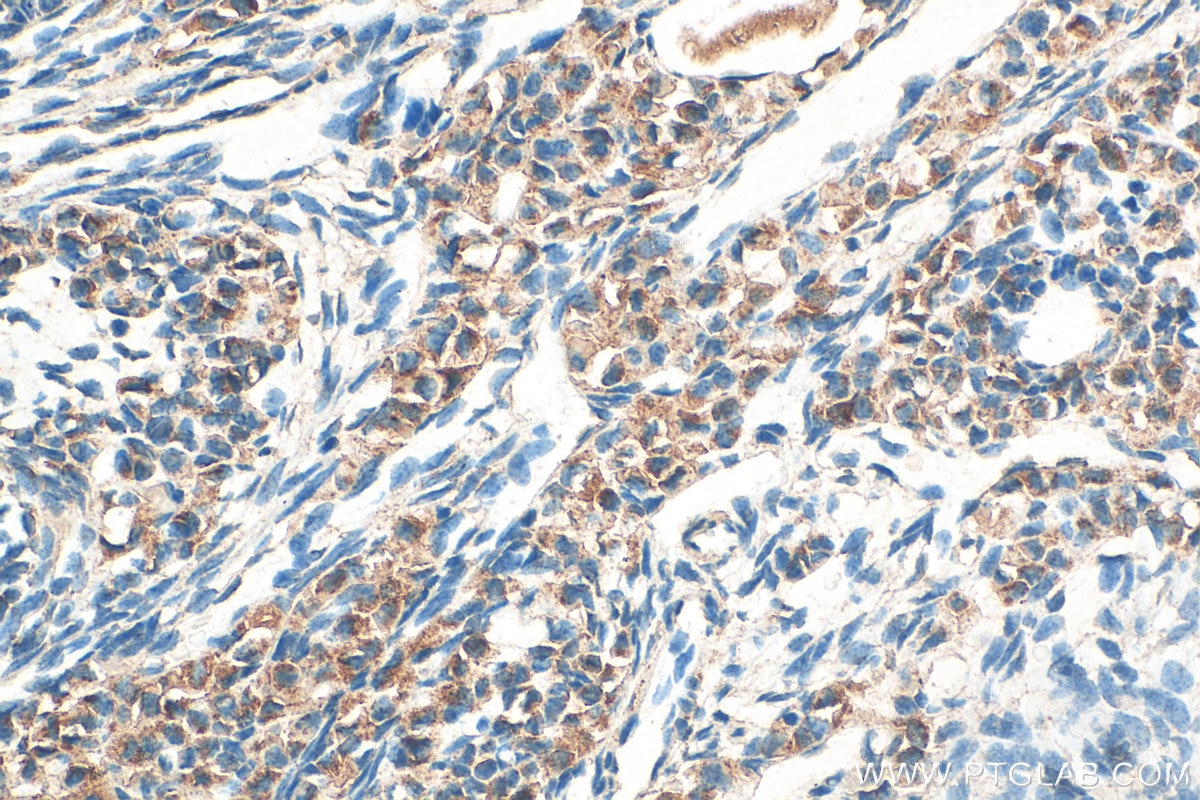
Immunohistochemistry (IHC) staining of mouse ovary tissue using ST3GAL4 Polyclonal antibody (13546-1-AP)

Tested Applications
| Positive WB detected in | HeLa cells, HCT 116 cells, HepG2 cells, MCF-7 cells, MDA-MB-231 cells |
| Positive IHC detected in | mouse ovary tissue, human skin tissue, human testis tissue Note: suggested antigen retrieval with TE buffer pH 9.0; (*) Alternatively, antigen retrieval may be performed with citrate buffer pH 6.0 |
Recommended dilution
| Application | Dilution |
|---|---|
| Western Blot (WB) | WB : 1:5000-1:15000 |
| Immunohistochemistry (IHC) | IHC : 1:50-1:500 |
| It is recommended that this reagent should be titrated in each testing system to obtain optimal results. | |
| Sample-dependent, Check data in validation data gallery. | |
Published Applications
| WB | See 4 publications below |
| IHC | See 5 publications below |
| IF | See 2 publications below |
Product Information
13546-1-AP targets ST3GAL4 in WB, IHC, IF, ELISA applications and shows reactivity with human, mouse samples.
| Tested Reactivity | human, mouse |
| Cited Reactivity | human, mouse |
| Host / Isotype | Rabbit / IgG |
| Class | Polyclonal |
| Type | Antibody |
| Immunogen |
CatNo: Ag3665 Product name: Recombinant human ST3GAL4 protein Source: e coli.-derived, PGEX-4T Tag: GST Domain: 1-333 aa of BC010645 Sequence: MVSKSRWKLLAMLALVLVVMVWYSISREDRYIELFYFPIPEKKEPCLQGEAESKASKLFGNYSRDQPIFLRLEDYFWVKTPSAYELPYGTKGSEDLLLRVLAITSSSIPKNIQSLRCRRCVVVGNGHRLRNSSLGDAINKYDVVIRLNNAPVAGYEGDVGSKTTMRLFYPESAHFDPKVENNPDTLLVLVAFKAMDFHWIETILSDKKRVRKGFWKQPPLIWDVNPKQIRILNPFFMEIAADKLLSLPMQQPRKIKQKPTTGLLAITLALHLCDLVHIAGFGYPDAYNKKQTIHYYEQITLKSMAGSGHNVSQEALAIKRMLEMGAIKNLTSF Predict reactive species |
| Full Name | ST3 beta-galactoside alpha-2,3-sialyltransferase 4 |
| Calculated Molecular Weight | 333 aa, 38 kDa |
| Observed Molecular Weight | 36 kDa |
| GenBank Accession Number | BC010645 |
| Gene Symbol | ST3GAL4 |
| Gene ID (NCBI) | 6484 |
| RRID | AB_10597402 |
| Conjugate | Unconjugated |
| Form | Liquid |
| Purification Method | Antigen affinity purification |
| UNIPROT ID | Q11206 |
| Storage Buffer | PBS with 0.02% sodium azide and 50% glycerol, pH 7.3. |
| Storage Conditions | Store at -20°C. Stable for one year after shipment. Aliquoting is unnecessary for -20oC storage. 20ul sizes contain 0.1% BSA. |
Background Information
ST3GAL4, also known as CGS23, NANTA3 and SIAT4C, is a member of the glycosyltransferase 29 family. ST3GAL4 protein exists in multiple splice variants and is frequently modified by glycosylation. ST3GAL4 is expressed uniformly in tissues and organs during all stages of development, and the subcellular localization is currently not clear.
Protocols
| Product Specific Protocols | |
|---|---|
| IHC protocol for ST3GAL4 antibody 13546-1-AP | Download protocol |
| WB protocol for ST3GAL4 antibody 13546-1-AP | Download protocol |
| Standard Protocols | |
|---|---|
| Click here to view our Standard Protocols |
Publications
| Species | Application | Title |
|---|---|---|
Front Oncol ST3Gal IV Mediates the Growth and Proliferation of Cervical Cancer Cells In Vitro and In Vivo Via the Notch/p21/CDKs Pathway. | ||
Sci Rep Five hypoxia and immunity related genes as potential biomarkers for the prognosis of osteosarcoma. | ||
FEBS Lett The sialyltransferase ST3Gal3 facilitates the receptivity of the uterine endometrium in vitro and in vivo. | ||
Biochim Biophys Acta Mol Basis Dis Sialyltransferase ST3GAL4 directs a dual mechanism to promote pancreatic ductal adenocarcinoma progression by regulating endoplasmic reticulum stress and mitochondrial homeostasis | ||
Adv Sci (Weinh) A Glycoproteome Data Mining Strategy for Characterizing Structural Features of Altered Glycans with Thymic Involution | ||
Elife scRNA-seq and scATAC-seq reveal that Sertoli cell mediates spermatogenesis disorders through stage-specific communications in non-obstructive azoospermia |